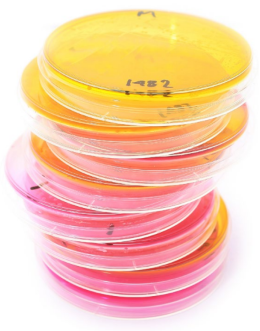

Представьте, что вы учёный, исследующий очень редкое животное, обитающее в джунглях Амазонки. Вам нужно не только изучить его внешнее и внутреннее строение, но и узнать, что записано в генах. Неужели, чтобы получить полную информацию о животном, надо каждый раз калечить новую особь — например, отрезать у неё кусочек уха — в погоне за биоматериалом? Конечно нет. Нам помогут клеточные культуры — модели живого организма in vitro («в пробирке»).
Микрофотография клеток линии HeLa

Первичные культуры
Наиболее точной моделью отдельной ткани служат первичные культуры, взятые непосредственно из организма. Кусочек ткани разрушают механически и с помощью ферментов (например, коллагеназы). Структура большинства тканей формируется благодаря так называемому внеклеточному матриксу, в котором, как кирпичи в цементе, закреплены клетки. Коллагеназа разрушает коллаген — главный компонент матрикса. Так получается культура, в которой можно наблюдать за отдельными клетками.
Полученные свободные клетки помещают в сосуды с плоским дном (чашку Петри, планшет, культуральный флакон) и заливают питательной средой, которая содержит углеводы, соли, аминокислоты, витамины, жирные кислоты и белки.
Кроме того, клетки нуждаются в углекислом газе. CO2 растворяется в среде, образуя бикарбонат-ионы HCO — 3 , которые поддерживают кислотность среды (рH) в комфортном для клеток диапазоне рН = 7,2–7,4.
Чтобы избежать губительных скачков кислотности, клетки в питательной среде помещают в CO2 -инкубатор, где создаётся подходящая для жизни клеток концентрация углекислого газа в воздухе.
Клетки осаждаются на дно посуды и начинают делиться, покрывая поверхность плотным слоем. Через некоторое время их пересаживают в новую посуду.

Первичные культуры сохраняют характеристики ткани, из которой были взяты, потому что не успели измениться по сравнению с тканью-предшественником. Именно поэтому результаты экспериментов на них можно переносить на целый организм. Однако у этого метода есть существенный недостаток. Подобно другим нормальным клеткам организма, они делятся конечное число раз, после чего перестают расти и погибают. Эта особенность называется репликативным старением и заключается в том, что перед каждым новым делением клетки хромосомы дочерней клетки оказываются короче хромосом материнской. Итак, через некоторое время культивируемые клетки погибают — требуется новый образец ткани, но его получение сопряжено с серьёзными затратами, а иногда и вовсе невозможно.
Ёмкости с клеточными культурами. В среду добавляют краситель феноловый красный, позволяющий визуально контролировать уровень кислотности. При оптимальных значениях он розовый, в более кислой среде жёлтый, в более щелочной бордовый.

Клетки соединительной ткани — фибробласты — «приклеиваются»к поверхности, распластываются и делятся, пока не образуется сплошной монослой.


КЛЕТОЧНОЕ ДЕЛЕНИЕ И СОКРАЩЕНИЕ ТЕЛОМЕР
Иммортализация
Эту проблему можно решить, используя постоянные клеточные линии: они делятся без ограничений и живут вечно. Существует несколько способов получить постоянную культуру. Самый простой — добыть клетки из опухоли. Однако они подверглись патологическим изменениям и могут не отражать процессы в здоровых тканях.
Другой вариант — трансформировать клетки первичной культуры с помощью вирусов или генетической мутации. Этот процесс называется иммортализация. Клетка приобретает способность к неограниченному количеству делений. Переход к бессмертию может происходить спонтанно, а может быть индуцирован.
Чтобы получать иммортализованные клетки, больше похожие на здоровые клетки организма и мало изменившие свою жизнедеятельность, была отработана методика введения гена теломеразы в геном клетки. Концевые участки хромосом — теломеры — сокращаются при каждом делении клетки; когда они становятся непозволительно короткими, клетка включает механизм самоуничтожения. Доставленная в такую клетку теломераза помогает наращивать уменьшившиеся после деления концы, что позволяет подолгу использовать их в экспериментах.
Иммортализованные линии не только бесконечно делятся, но и переживают многократные заморозки в жидком азоте — именно так хранятся клетки во всех лабораториях мира.
К сожалению, у иммортализованных клеточных линий есть очевидные минусы. Такие культуры нестабильны: чем дольше клетки культивируются, тем больше делений они претерпевают, а значит, тем выше вероятность мутаций в ДНК. Культура перестаёт быть похожа на изначальную, поэтому исследователь не сможет адекватно оценить процессы, идущие в иммортализованных клетках, и сравнить их с жизнедеятельностью клеток в живом организме. Зачем же учёные продолжают работать с постоянными клеточными линиями и тратить столько времени на их идентификацию? Бессмертие, конечно, главная причина использования таких линий. Это довольно удобно, а главное, дёшево по сравнению с затратами на выращивание первичных культур. Поэтому сегодня иммортализованные клеточные линии применяются в самых разных областях: от изучения сигнальных путей в клетках до создания антител и вакцинных препаратов.

Вторая жизнь Генриетты
В феврале 1951 года жительница штата Мэриленд (США), молодая афроамериканка Генриетта Лакс (Henrietta Lacks), обратилась в госпиталь Университета Джонса Хопкинса. У неё подозревали рак шейки матки, и через несколько дней этот диагноз был подтверждён. Несмотря на старания врачей и перенесённые операции, Генриетта умерла от рака в октябре того же года. Печальная, но не редкая в те годы смерть. Кто бы мог подумать, что спустя почти 70 лет имя этой женщины будет знакомо каждому биологу!
Во время лечения врач Генриетты передал опухолевый материал заведующему лабораторией исследования клеток тканей Джорджу Гею. Раковые клетки были совсем не похожи на клетки, с которыми учёный имел дело раньше: они размножались вдвое быстрее обычных и не прекращали делиться. Джордж Гей назвал эту линию по первым буквам имени и фамилии Генриетты — HeLa.
Отныне стало возможно изучать процессы в клетках человека и не бояться, что они погибнут до окончания эксперимента. Клетки HeLa настолько неприхотливы, что на них можно исследовать воздействие радиации и проверять влияние невесомости. Линия клеток, идентичная во всех лабораториях мира, позволила быстро получать и независимо подтверждать всё новые и новые данные. На сегодня опубликовано около 70 000 работ, авторы которых использовали клетки HeLa. По меньшей мере три Нобелевские премии были присуждены за исследования с участием этих клеток: за открытие вирусов папилломы человека, вызывающих рак шейки матки (Харальд цур Хаузен, 2008 год); за открытие вируса иммунодефицита человека (Франсуаза Барре-Синусси и Люк Монтанье, 2008 год); за открытие того, как теломеры и фермент теломераза защищают хромосомы (Элизабет Блэкбёрн, Кэрол Грейдер и Джек Шостак, 2009 год).
ПОЧЕМУ HELA БЕССМЕРТНЫ
Бессмертие клеток линии HeLa связывают с последствиями инфицирования вирусом папилломы человека HPV18. Злокачественная вирусная трансформация вызвала аномальные генетические изменения: в ядре каждой клетки HeLa от 76 до 82 хромосом (в нормальных клетках человека — 46); повышена активность ряда регуляторов клеточного роста (например, генов теломеразы). Эти уникальные и случайные изменения сделали HeLa таким же культовым объектом в мире биотехнологий, как чашки Петри и лабораторные мыши.

Селезёнка Джона Мура
При использовании клеточных культур, полученных от животных или человека, неизбежно возникают вопросы этики. Считается, что, когда это возможно, животных необходимо заменять другими биологическими моделями, например культурами клеток тканей. Получение таких культур жёстко регламентируется специальными правилами, которые составляют этические комитеты научных центров. При работе с человеческими органами и тканями нюансов гораздо больше. Например, неизбежный вопрос: нужно ли платить компенсацию родственникам за использование клеток близкого человека? В случае Генриетты Лакс этот вопрос так и не был решён, но долго оставаться без ответа он не мог.
Первое официальное решение по вопросу этичности использования клеток пациента было вынесено Верховным судом штата Калифорния 9 июля 1990 года.
В 1976 году Джон Мур проходил лечение в медицинском центре UCLA. У него была диагностирована лейкемия. Обеспокоенный тем, что опасно распухшая селезёнка больного может лопнуть, лечащий врач Дэвид Голд порекомендовал удалить больной орган. Мур подписал согласие на операцию и благополучно её перенёс.
Изучив ткань удаленной селезёнки, Голд увидел, что клетки Джона Мура уникальны. Они производили белок, который стимулировал рост лейкоцитов, а это могло помогать борьбе с инфекциями. В течение следующих нескольких лет Голд и его коллеги выделили из тканей Мура клеточную линию и получили на неё патент, который принёс им значительный доход. Узнав об этом, Мур обратился с иском в суд штата, утверждая, что должен был бы разделить прибыль от препарата, полученного из его клеток и разработанного без его ведома и согласия.
После долгих споров Верховный суд Калифорнии решил, что пациенты не имеют прав собственности на линии клеток, полученных из органов, которые удалили с их согласия. Однако признал, что «врач, который добивается согласия пациента на медицинскую процедуру, должен…раскрывать личные интересы, не связанные с состоянием здоровья пациента, будь то исследования или экономические последствия, которые могут повлиять на его медицинское заключение».
Сегодня вариантов клеточных линий сотни, для них выпускают культуральную посуду всех типов и уникальную питательную среду. Дело за малым — досконально обдумать дизайн эксперимента, который наилучшим образом смоделирует процессы, протекающие в живой клетке.
ПОЛУЧЕНИЕ ИММОРТАЛИЗОВАННОЙ КУЛЬТУРЫ
В 1960-е годы учёные обнаружили, что клетки из раковых опухолей (лимфом и карцином) могут хорошо делиться и долго существовать в культуре. Оказалось, что почти все такие клетки содержат вирус герпеса человека 4-го типа (вирус Эпштейна — Барр). Проверив реакцию разных типов клеток на этот вирус, исследователи заметили, что он активно заражает B-лимфоциты, но при этом не убивает их, а, наоборот, стимулирует рост. Поэтому заражение герпес-вирусом стало основным методом иммортализации B-лимфоцитов.

Из организма берут несколько миллилитров крови и дожидаются её расслаивания: безъядерные эритроциты оседают на дне, в плазме сверху остаются все ядросодержащие клетки, в том числе лимфоциты. Затем полученную первичную культуру заражают вирусом.

Через несколько дней после заражения производят селекцию, чтобы избавиться от клеток, которые участвуют в иммунном ответе против вируса.

Когда B-лимфоциты начинают активно делиться и образовывать конгломераты, считается, что иммортализация прошла успешно.

Чтобы клетки сохранились практически в исходном состоянии, их замораживают в специальной среде и после заморозки держат в криохранилищах с жидким азотом.